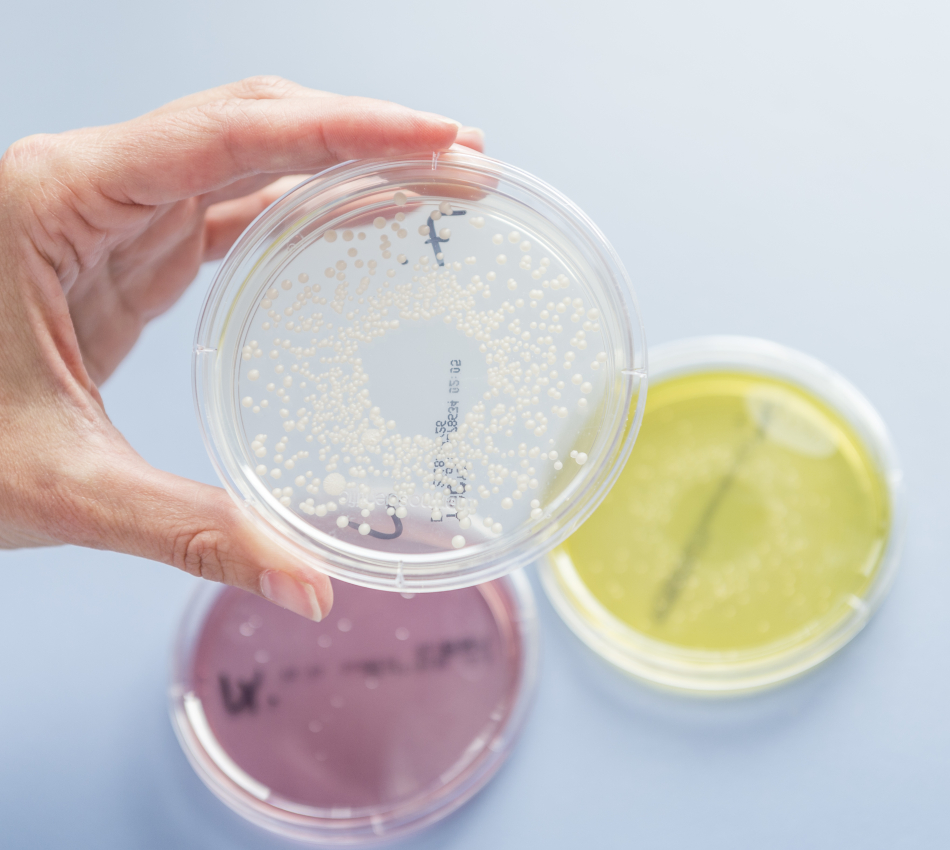

Laboranalytik Rohwaren und Lebensmittel
Ihre Hauptvorteile
- Kontrollierte Qualität für Ihr Produkt
- Umfassende Inhouse Expertenberatung
- Professionelle Risikoanalysen
Viele Handelskunden, aber auch immer mehr Endverbraucher fordern eine lückenlose Kontrolle der Produktqualität vom Rohstoff bis hin zu den verkaufsfähigen Backwaren.
Bei DIOSNA bieten wir Ihnen die Expertise, um Risikoanalysen durchzuführen und die notwendigen Laboranalysen zu initiieren.